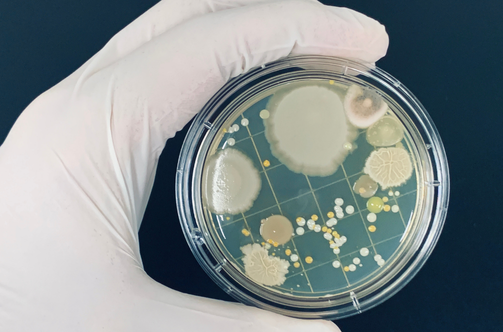

About Us

Simurgh BioScience is a young biotech startup located in Dicle University Technopark. As an academic spin-off, we are driven by the belief that nature holds untapped potential for solving today’s medical challenges. Our work focuses on discovering new drug candidates from microorganisms by unlocking the hidden potential in their genomes and chemistry.
- Discovering new drug candidates from microorganisms
- Unlocking genetic and chemical potential
- Contributing to health and sustainability through nature-inspired innovation
OUR DISCOVERY PIPELINE
Unleashing the Power of Microbial Natural Products
Exploration & Isolation
Targeted Microbial Prospecting
Selective isolation of microorganisms from extreme and unexplored habitats, combined with advanced cultivation techniques to unlock hidden biosynthetic potential.
Selective isolation of microorganisms from extreme and unexplored habitats, combined with advanced cultivation techniques to unlock hidden biosynthetic potential.

Omics-Driven Insights
Multi-Omics Profiling & AI-Powered Discovery
Integrative genomics, transcriptomics, and metabolomics analyses coupled with cutting-edge bioinformatics and artificial intelligence to accelerate the identification of novel bioactive metabolites.
Integrative genomics, transcriptomics, and metabolomics analyses coupled with cutting-edge bioinformatics and artificial intelligence to accelerate the identification of novel bioactive metabolites.

Functional Screening & In Silico
Design and Engineering
Comprehensive screening for antimicrobial, antiviral, anticancer, and other therapeutic activities, alongside in silico drug-target interaction modeling to predict pharmacological relevance.
Comprehensive screening for antimicrobial, antiviral, anticancer, and other therapeutic activities, alongside in silico drug-target interaction modeling to predict pharmacological relevance.

Synthetic Biology
Pathway Activation & Heterologous Expression
Synthetic biology strategies, including heterologous expression systems, to activate cryptic biosynthetic gene clusters and enable scalable production of target secondary metabolites.
Synthetic biology strategies, including heterologous expression systems, to activate cryptic biosynthetic gene clusters and enable scalable production of target secondary metabolites.
Blog/News
Coming Soon
Stay tuned for updates, stories, and news from Simurgh BioScience.
Projects & Collaborations
Coming Soon
Our current projects and collaborations will be listed here soon.

Feel free to contact us:
- Yiğitçavuş Mah. Silvan Blv. Dicle Teknokent Sur, 21200 Diyarbakır (Türkiye)
- simurghbioscience.com
- simurghbioscience@gmail.com

